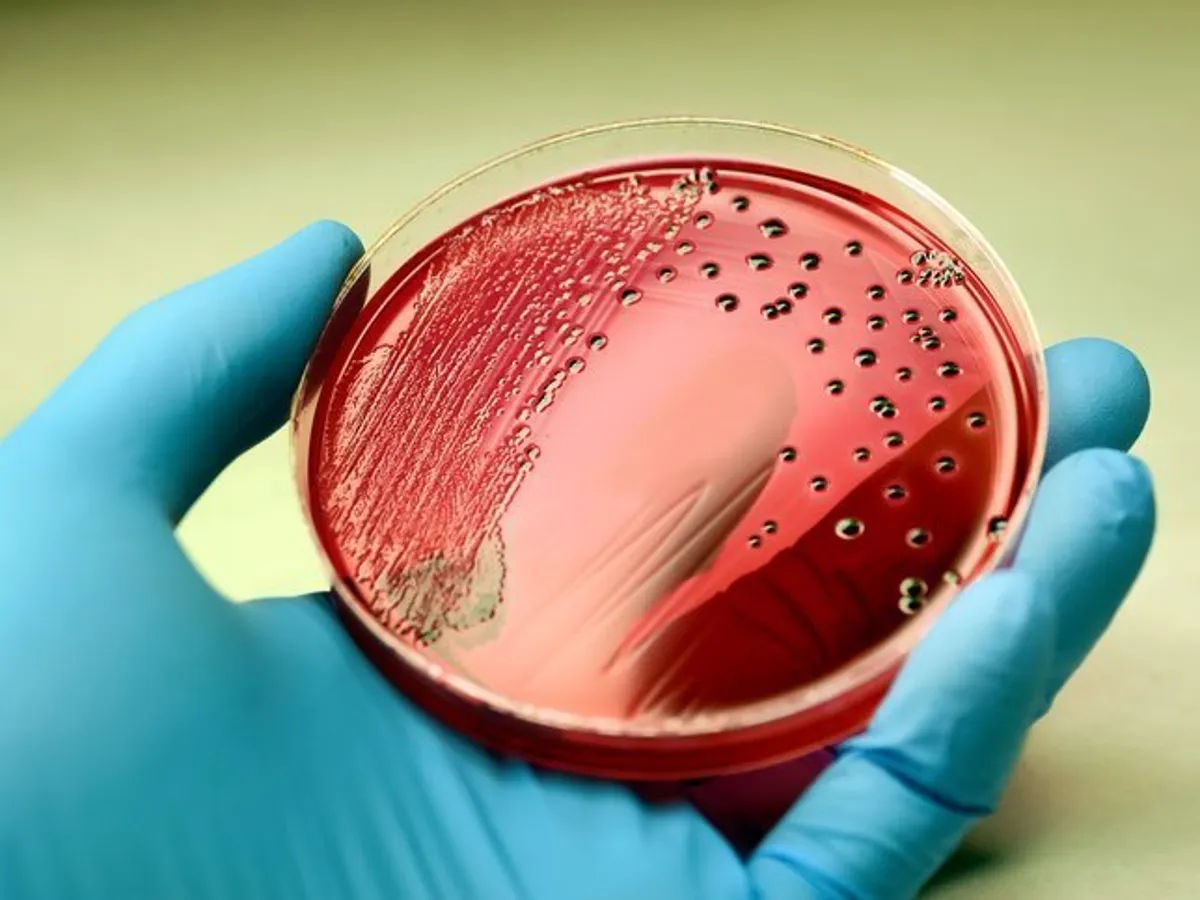

Cum este contaminată mâncarea cu Salmonella
Producătorii americani ai biscuiților Goldfish au retras 3,3 milioane de pachete de pe piață, din cauza suspiciunii că produsele ar putea fi contaminate cu salmonella. Dar ce este această bacterie, de ce este atât de periculoasă și cum ajunge în mâncare?
Salmonella este numele folosit pentru aproape 2.000 de tipuri de bacterii care pot declanșa crampe abdominale, diaree și febră, care durează între patru și șapte zile. Cei care sunt infectați pot experimenta, de asemenea, dureri de cap și de mușchi. Aceste simptome apar, de obicei, între 6 și 72 de ore, după ce bacteria este ingurgitată.
Numai în SUA, în fiecare an, salmonella îmbolnăvește peste 1,2 milioane de oameni, dintre care 23.000 ajung la spital. 450 de persoane chiar mor, anual, scrie Newsweek.
În condițiile în care majoritatea cazurilor de samonella nu sunt tratabile cu antibiotice, cei care se infectează trebuie pur și simplu să lase propriul sistem imun să elimine bacteriile. Trebuie doar să bea multe fluide, pentru a evita dezhidratarea.
Totuși, dacă diaree este severă, pacienții pot avea nevoie de internare, pentru a preveni dezhidratarea severă. În unele cazuri rare, bacteria poate trece în fluxul de sânge, iar dacă nu se intervine cu tratament, se poate ajunge până la moarte.
Cei care au un sistem imun slab, precum copiii sub cinci ani sau bătrânii, riscă, în unele cazuri, complicații serioase.
Uneori, persoanele infectate cu salmonella pot să nu prezinte simptomele menționate. Totuși, rămân transmițători ai bacteriei, prin fecale. De aceea este esențială igiena mâinilor, după folosirea toatelei și înainte de prepararea mâncării.
Salmonella trăiește, în general, în tractul intestinal al oamenilor și animalelor, iar mâncarea se contaminează atunci când vine în contact cu materii fecale infestate. De obicei, cele mai afectate sunt produsele de origine animală – precum carne, produse lactate și ouă – dar chiar și fructele sau cerealele pot transporta bacteria.
Și cum aceasta este microscopică, mâncarea nu va prezenta nici o modificare vizibilă cu ochiul liber, așa încât nu aflăm că ne-am infectat decât când e prea târziu.
În cazul biscuiților Goldfish, s-a bănuit că făina a fost responsabilă pentru contaminarea cu salmonella.




















